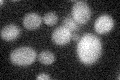
YER146W
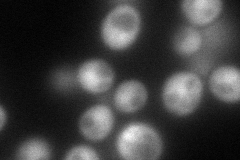
YER146W
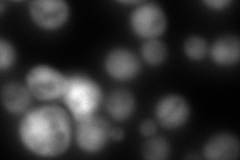
YER146W
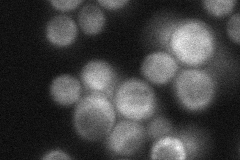
YER146W

View description
Lsm (Like Sm) protein; part of heteroheptameric complexes (Lsm2p-7p and either Lsm1p or 8p): cytoplasmic Lsm1p complex involved in mRNA decay; nuclear Lsm8p complex part of U6 snRNP and possibly involved in processing tRNA, snoRNA, and rRNA
Localization:
Intensity:
Fold change:
Significance:
-
C’ GFP library in SD
below threshold16.83 -
N' NOP1pr-GFP in SD
cytosol133.632 -
N' TEF2pr-mCherry in SD
cytosol30.9263 -
N' NATIVEpr-GFP in SD
cytosol,punctate38.3228 -
N' TEF2pr-VC and Cyto-VN in SD

#N/A0 -
C’ GFP library in SD+DTT

cytosol16.951No -
C’ GFP library in SD+H2O2

cytosol15.360.91No -
C’ GFP library in Starvation Media

cytosol14.120.83No -
C’ GFP library on the background of Pup2-DaMP

below threshold -
C’ GFP library on the background of CCT mutant

below threshold15.4630.918301No
